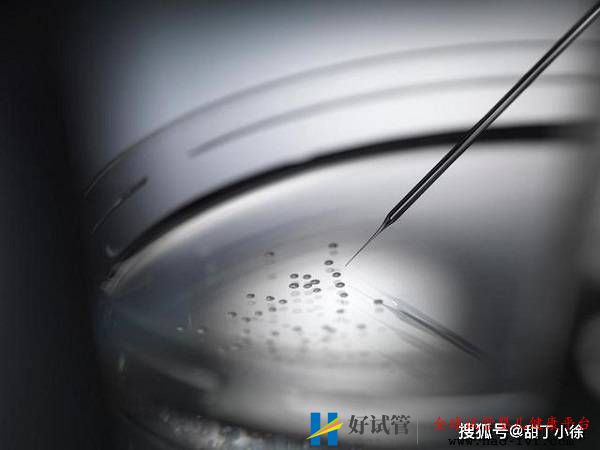

直观分析试管婴儿成功率高吗
原标题:直观分析试管婴儿成功率高吗
试管婴儿的成功率高吗?一直是想要试管人群所关心的问题。虽然第三代试管婴儿技术是目前治疗不孕不育有效的方法,而且被众人选择,但试管的成功率并不是百分之百的,和很多因素都有关。如下:
年龄因素
试管婴儿成功率高吗?与年龄有很大的关系。年龄在试管婴儿成功率中影响大,35岁以上女性,成功率逐渐下降,当40岁时试管婴儿的成功约20%。因为女性卵巢功能直接受女性年龄影响,精子与卵子是培育生命的主要条件,如果精子和卵子的条件好,成功率就高。
子宫条件
试管婴儿成功率高吗?和子宫有关。子宫环境是胚胎生长发育的地方,尤其是子宫内膜直接影响胚胎着床。子宫内膜如果够厚、血流丰富而且细胞分裂良好,会增加胚胎着床率,反观子宫内膜太薄,胚胎就不容易着床。如果子宫畸形、严重的子宫内膜异位症、卵子异常及输卵管积水等原因不孕者等,在试管婴儿治疗中的失败率较高。
精液因素
生育是两个人的事,男性精虫的数目及活动力直觉取决于卵子受精的情况。
医生技术
胚胎植入手术是试管婴儿成功的要件之一,将胚胎放在容易着床的位置,这对做好试管婴儿的成功率就大大提高。
患者情绪
试管婴儿成功率高吗?与情绪有一定的关系。一般乐观的患者试管婴儿成功率会比悲观的患者成功率高,过度的心理紧张容易引起内分泌失调,从而导致胚胎难以着床。
试管婴儿成功率高吗?做试管婴儿要做好一系列准备,如:约束自我,不抽烟、不喝酒、无应酬、少熬夜等。好好调养自己的身体,定时做体检,选择合适的治疗方案及选择专业的试管婴儿医院等,这些都有利于提高试管婴儿成功率。





